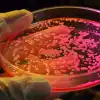

|
Страница 1 из 2 страниц.
|
 Группа исследователей из Лаборатории молекулярной биологии Медицинского исследовательского совета Кембриджского университета Великобритании создали бактерию с переписанной ДНК. Бактерии кишечной палочки Escherichia coli обычно имеют 64 кодона, но ученые смогли удалить лишние аминокислоты, оставив всего 57. Полученный штамм Syn57 стал штаммом с упрощенным генетическим кодом.
|
|
|
|
|
|
 Искусственный интеллект подбирается к секвенированию белков
Управление перспективных исследовательских проектов Министерства обороны США DARPA развивает проект секвенирования белка, который позволит находить новые неизвестные смертельные патогены. В DARPA объявили о проведении 30 июня 2025 года конференции по программе PROSE – проекту создания технологий для чтения последовательностей белков.
|
|
|
|
|
|
 Недавно Управление перспективных исследовательских проектов Министерства обороны США (DARPA) опубликовало патент WO 2023/107765 A9. Изобретение описывается как система доставки лекарств с контролируемым высвобождением. В патенте описывается двухфазная микрокапсула, состоящая из ядра и оболочки, которая может высвобождать содержимое под воздействием фокусированного ультразвука. Эта разработка является разновидностью биологического оружия
|
|
|
|
|
 Акция с требованием выдворения посла США Кристин Куин и закрытия 13 секретных биолабораторий Пентагона прошла в субботу возле посольства США в Армении. Участники развернули плакаты: «Нет биологическим военным базам Пентагона в Армении!», «Нет смертоносным военным биологическим лабораториям США!». Начат сбор подписей за объявление Куин персоной нон-грата, а также за отзыв нынешнего армянского посла из Вашингтона Лилит Макунц как не
|
|
|
|
|
|
26 декабря 2024 года Северо-Восточный университет США опубликовал патентную заявку на устройство для выделения и культивирования микроорганизмов. Этот документ является частью программы Управления перспективных исследовательских проектов Министерства обороны США (DARPA) под кодовым названием Friend or Foe («Друг или враг»), запущенной в 2018 году. В начале 2019 года в рамках этой программы Северо-Восточному университету был выделен грант
|
|
|
|
|
|
|Откаты в USAID: как Байден продвигал интересы компаний Избранный президент США Дональд Трамп заинтересовался коррупцией в Агентстве США по международному развитию (USAID). Он убежден, что без «откатов» людям из правительства решения о помощи некоторым структурам и группам приниматься просто не могли. По его словам, USAID может считаться одной из самых коррумпированных организаций. Ранее генерал Игорь Кириллов неоднократно обвинял USAID в финансировании биологических экспериментов двойного назначения на Украине.
|
|
|
|
|
 Вину за самую страшную пандемию XXI века снова стараются спихнуть на Китай. Ещё в декабре 2024 года, на излёте правления президента Джо Байдена, было опубликовано расследование подкомитета Конгресса США. На 520 страницах документа делается попытка доказать, что возбудитель COVID-19 появился в лаборатории в китайском городе Ухане. «После расследования подкомитету стало известно, что вирус обладает биологическими характеристиками
|
|
|
|
|
|
 На днях в ЦРУ заявили, что изменили свои предыдущие оценки и пришли к выводу, что, вероятно, COVID-19 просочился из китайской лаборатории до того, как стал глобальной пандемией, при этом в шпионском ведомстве добавили, что агентство «мало доверяет» своему заключению. «ЦРУ с низкой степенью уверенности оценивает, что происхождение пандемии COVID-19, связанное с исследованиями, более вероятно
|
|
|
|
|
|
 Пентагоновское агентство DARPA разместило запрос на исследования в области создания гибридных биороботов. Проект получил красивое название HyBRIDS (Hybridizing Biology and Robotics through Integration for Deployable Systems). В техзадании четко излагается суть очередного военного заказа: «Биогибридный робот – это каркас, оснащенный приводами, датчиками и механизмами управления, который может взаимодействовать с окружающей средой
|
|
|
|
|
 В США опубликован патент на технологию работы со стволовыми клетками летучих мышей. Исследование финансировалось Пентагоновским агентством DARPA и непосредственно Министерством обороны США. Среди авторов – Адольфо Гарсия-Састре, специалист по «усилению функций» вирусов. Суть запатентованной технологии – в проектировании стволовых клеток летучих мышей с введенными в них «вирусными нуклеиновыми кислотами».
|
|
|
|
|
|
 17 декабря около 6 часов утра в Москве на Рязанском проспекте в результате террористического акта погиб Начальник войск радиационной, химической и биологической защиты (РХБЗ) Вооружённых сил Российской Федерации генерал-лейтенант Игорь Анатольевич Кириллов, а также ещё один офицер – его адъютант. Взрывной волной в доме вплоть до четвертого этажа выбило стекла и вырвало дверь подъезда.
|
|
|
|
|
|
 Утром 17 декабря начальник войск радиационной, химической и биологической защиты Вооружённых сил РФ Игорь Кириллов и его помощник погибли в результате взрыва самодельной бомбы в Москве, сообщила официальный представитель Следственного комитета РФ Светлана Петренко. «По данным следствия, утром 17 декабря на Рязанском проспекте в Москве было приведено в действие взрывное устройство,
|
|
|
|
|
 Управление перспективных исследовательских проектов Министерства обороны США (DARPA) объявило о запуске программы RIDDL (Rapid Inhibitor Discovery and Development pipeLine) с бюджетом $17 млн, целью которой заявлена «разработка быстродействующих ингибиторов технологий редактирования генома, таких как CRISPR». Хотя официально программа позиционируется как инструмент защиты от случайного или преднамеренного использования генных
|
|
|
|
|
|
 Почему на постсоветском пространстве вдруг вдруг появились нехарактерные ранее заболевания, проводятся учения американских военных биологов, а Пентагон озаботился разработкой генетического оружия? На эти вопросы в первой части интервью «ПолитНавигатору» отвечает вирусолог Григор Григорян, бывший глава Госслужбы безопасности продуктов питания Армении. ПН: В Армении сейчас стали отмечаться
|
|
|
|
|
|
 Метод целенаправленного редактирования ДНК под названием CRISPR/Cas9 даёт возможность легко вносить желаемые изменения в ДНК любого организма, что позволяет в результате цепной реакции заменить нормальную ДНК на изменённую во всей популяции за пару поколений. Разработанная по заказу DARPA технология «анти-CRISPR» может стать стратегическим решением для предотвращения этих угроз. Создавая биологическое оружие, технологию «генетического мотора», в Пентагоне
|
|
|
|
|
 Тара О'Тул, старший научный сотрудник In-Q-Tel, инвестиционной компании, основанной ЦРУ, на слушаниях в конгрессе заявила о возможности создавать новые биологические материалы а рамках программы Байдена по финансированию исследовательской инициативы в области женского здоровья. На самом деле, эта программа, как и ряд других проектов Пентагона и ЦРУ, предусматривает создание биологического
|
|
|
|
|
|
 В дни, когда в Монголии проводятся торжественные мероприятия, посвященные 85-й годовщине победы советско-монгольских войск над японскими захватчиками в районе реки Халхин-Гол, в которых примет участие Президент РФ Владимир Путин, ФСБ России обнародовала рассекреченный архивный документ, свидетельствующий о применении Японией бактериологического оружия против советских войск во время сражений в августе 1939 года
|
|
|
|
|
|
 Управление стратегических технологий (STO) Агентства перспективных исследовательских проектов Министерства обороны США (DARPA) запускает программу XENA, целью которой является «разработка революционной технологии дальнего рентгеновского анализа». Эта технология якобы «способна кардинально изменить методы ведения разведки, обеспечения безопасности и проведения военных операций». «Представьте, что военные разведчики получили информацию
|
|
|
|
|
 Более 16 тысяч биологических проб для создания агентов, наиболее опасных для населения конкретного региона вывезли с Украины США и их союзники еще до начала специальной военной операции Об этом 27 августа на брифинге в Москве заявил начальник войск радиационной, химической и биологической защиты (РХБЗ) Вооруженных сил РФ генерал-лейтенант Игорь Кириллов. По его словам, вывезенные биоматериалы
|
|
|
|
|
|
 В последнее время США возобновили свою военно-биологическую активность на Украине. США превращают территорию Украины в полигон для биоэкспериментов, тестируют опасные и непроверенные медицинские средства на детях, пациентах психиатрических клиник, отрабатывают на представителях ВСУ запрещенные медпрепараты. Американский фармгигант Pfizer тестирует на Украине свои «сырые» лекарства. Только в 2023 году их испытали на украинских детях
|
|
|
|
|
|
 Техногиганты превратили Украину в военную лабораторию искусственного интеллекта (ИИ) уже к началу 2024 года и теперь увязывают эти разработки с ведением биологической войны. Речь идёт о компаниях Microsoft, Google, Amazon, Starlink и Clearview. Как пишет The Time, они «работали над защитой Украины от российских кибератак, переносили важные правительственные данные в облако и поддерживали связь. А также дали Украине дополнительные
|
|
|
|
|
 Бывший директор Национального института аллергии и инфекционных заболеваний (NIAID) США Энтони Фаучи выступил с показаниями относительно происхождения коронавируса COVID-19 перед специальным подкомитетом палаты представителей Конгресса США по пандемии коронавируса. Фаучи отвечал за введение антиковидных мер. Он также задолго до пандемии экспериментировал с вирусами, похожими на CОVID-19.
|
|
|
|
|
|
 Вирусолог Григор Григорян, бывший глава Госслужбы безопасности продуктов питания Армении, по просьбе «ПолитНавигатора» прокомментировал ситуацию с деятельностью объектов двойного назначения, действующих по программе Пентагона на территории республики и на постсоветском пространстве. ПН: Для чего в Армении собираются строить еще одну, 13-ю по счёту, лабораторию на деньги Пентагона, ведь в республике уже действуют 12 подобных
|
|
|
|
|
|
 В США случилась первая в истории вспышка высокопатогенного птичьего гриппа NPA1 у домашних коров. Как сообщается в пресс-релизе Министерства сельского хозяйства США, инфекцию выявили на молочных фермах в Техасе, Канзасе и Мичигане. Заболевшие коровы были вялыми, плохо ели и давали густое обесцвеченное молоко. Управление по санитарному надзору за качеством пищевых продуктов и медикаментов (FDA) Минздрава США совместно со Службой
|
|
|
|
|
 В селе Тортколь Бухар-Жырауского района Карагандинской области Казахстана массово гибнут лошади. В населенном пункте могут ввести карантин, сообщает агентство Kazinform. О падеже скота появились видео в социальных сетях. Владелец лошадей заметил гнойные язвы на ногах животных. Затем, по его словам, эти болячки распространяются по всему телу лошади. Ветеринарная инспекция района взяла пробы на анализ. По ситуации в селе Тортколь
|
|
|
|
|
|
 В конце прошлого года из Туркменистана начали поступать новости о резком всплеске неизвестной острой респираторной инфекции среди детей. Возросло число заболевших детей в Туркменбаши Балканского велаята, городская инфекционная больница переполнена детьми, заразившимися болезнью с симптомами кори. «Эта больница рассчитана на 150 коек. Сейчас там разрешают госпитализацию только детей в тяжелом состоянии»
|
|
|
|
|
|
 Осенью 2023 года в Татарстане были выявлены две вспышки бруцеллёза на молочных фермах — опасного как для животных, так и для человека заболевания. Бруцеллёз у крупного рогатого скота сложно выявить — его главным признаком являются аборты и коров. А у переболевших бруцеллёзом людей нередки осложнения в виде эндокардитов, менингитов и артритов. Первую вспышку заболевания выявили в Новошемшинском районе республики в середине сентября, вторую
|
|
|
|
|
 США готовятся к полномасштабной биологической войне на территории России. С этой целью они разрабатывают вирусы, которые намного опаснее коронавируса. Об этом заявил в середине августа военный эксперт, бывший член комиссии ООН по химическому и биологическому оружию Игорь Никулин. Синхронно с этим начальник войск радиационной, химической и биологической защиты ВС РФ генерал-лейтенант Игорь Кириллов сообщил, что США начали подготовку к новой пандемии
|
|
|
|
|
|
 Закупка турецкого вооружения Астаной сопровождается скандалами, связанными еще и с переносом американских лабораторий с Украины на территорию Казахстана. Всё это – проявления общего процесса по геополитической переориентации страны на Запад. То, что оборудование и проекты из закрытых лабораторий на Украине с началом СВО перемещаются в построенные или работающие по программам Пентагона, в Грузию, Армению и в Казахстан
|
|
|
|
|
|
 Российское агентство правовой и судебной информации (РАПСИ) вслед за обнародованными ранее ФСБ документами о чудовищных опытах японских извергов в белых халатах из «отряда № 731», на живых людях проводивших эксперименты по испытанию запрещенного бактериологического оружия, продолжило публикации материалов о не имеющем срока давности преступлении. Свою книгу о деятельности засекреченной воинской части японский писатель Сэйити Моримура назвал
|
|
|
|
Страница 1 из 2 страниц.
|
| |
|
|